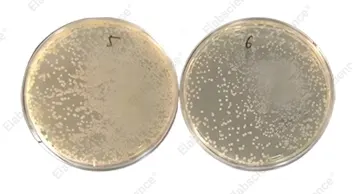

噬菌体展示技术是将外源外源蛋白或多肽的DNA序列插入到噬菌体外壳蛋白基因中,实现外源蛋白随噬菌体的重新组装而展示到噬菌体表面的生物技术。相较于传统杂交瘤技术,其在抗体筛选效率上提升百倍,可快速获得高亲和力候选分子,目前已成为抗体药物开发与诊断试剂优化的主流选择。
Elabscience® 可为客户提供不同物种的噬菌体展示文库构建及筛选服务,涵盖驼源VHH纳米抗体库、scFv抗体库、随机肽文库等,以满足客户的不同类型需求。
在线咨询噬菌体展示技术服务服务优势
库容多样性
构建超1×109 CFU免疫文库
知识产权保障
文库100%由客户独有
全流程托管
一站式服务,节省时间、精力和经费
技术路线

服务类型
纳米抗体定制服务
Elabscience® 致力为客户提供驼源VHH纳米抗体文库构建以及筛选服务。VHH纳米抗体分子量大小为15 kDa,目前被广泛应用于CAR-T/CAR-NK治疗性抗体开发。
在线咨询ScFv抗体定制服务
Elabscience® 致力为客户提供scFv文库构建即筛选抗体服务。scFv抗体可来自小鼠,大鼠,羊,兔子,人源等宿主的PBMC细胞。
在线咨询随机肽文库构建服务
Elabscience® 致力为客户提供随机肽文库构建及筛选服。在文库构中,Elabscience® 可根据客户需求设计可变区长度为5-20 AA随机肽。
在线咨询案例展示
案例1:小鼠scFv文库构建
Elabscience® 分离50只小鼠脾脏细胞,构建小鼠scFv文库,插入率为>95%,库容为1.1x109 CFU,随机挑选96株克隆进行测序,序列多样性>80%。

随机挑克隆,测序比对(部分)
案例2:随机肽文库构建
Elabscience® 合成基因库”Signal peptide-HHHHHH-GS-NNK(8)-GS-DDDDK-part of pIII”,设计引物扩增随机八肽片段,回收纯化目的条带后,进行噬菌体文库构建,库容量合计5.0x109 CFU。挑选96株克隆进行PCR鉴定,多样性大约为3.8x109 CFU。
库容量测定(5.0x109 CFU)

插入率检测(97.92%)
常见问题解答
1. 噬菌体展示技术的主要应用领域有哪些?
抗体开发:天然免疫文库、羊驼免疫库筛选VHH抗体。
多肽筛选:蛋白质互作、表位分析、酶抑制剂高通量筛选。
诊断与治疗:诊断试剂、疫苗载体优化及治疗性抗体(如阿达木纳米抗体)开发。
2. Elabscience® 如何质控噬菌体文库?
质控流程:
① 文库梯度稀释涂布平板,随机挑96株单克隆;
② 单菌落进行PCR,通过琼脂糖凝胶电泳来验证片段插入成功率(>95%);
③ 随机挑选48株单克隆测序验证文库的多样性。
3. Elabscience® 如何减少淘选中非特异性结合?
特异性优化方法:
① 封闭处理:封闭液封闭高丰度交叉的靶点;
② 去污剂优化:洗涤液降低噬菌体与靶分子之间的非特异性相互作用;
③ ELISA负筛选:ELISA排除非特异性克隆。
4. Elabscience® 噬菌体展示系统材料有哪些?
我司噬菌体展示系统核心组件:
① 载体:pComb3XSS-2;
② 宿主菌:感受态TG1;
③ 辅助噬菌体:M13K07。
在线咨询噬菌体展示技术服务
我们的技术支持会在收到需求表后第一时间与您联系,并根据您的需求提供专业的服务,您所填写的信息会被严格保密,敬请放心填写。
